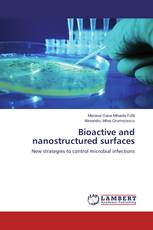
Bioactive and nanostructured surfaces

Messy Data in Heteroscedastic Models Case study: Mixed-Nested Design
Intesar El-Saeiti - ISBN: 978-3-659-68596-5
Non Carious Cervical Lesions
Priyanka S. Gadia, Meena Naganath, Deepak Mehta - ISBN: 978-3-659-68557-6
Bioactive and nanostructured surfaces
New strategies to control microbial infections
Mariana Oana Mihaela Fufă, Alexandru Mihai Grumezescu - ISBN: 978-3-659-32735-3
Витагенный опыт как средство обучения детей дошкольного возраста в ДОО
Монография
Ольга Некрасова - ISBN: 978-3-659-68100-4
Технология бюджетирования в системе управления организацией
Людмила Воронова, Руслан Воронов, Анна Куракина - ISBN: 978-3-659-66431-1
Оптимизация предупредительных замен и ремонтов технических устройств
Владислав Володарский - ISBN: 978-3-659-35149-5
Членение предложения при переводе искусствоведческих текстов
Юлия Привалова, Ольга Насонова - ISBN: 978-3-659-33823-6
Эффекты запутывания и интерференционные переходы в квантовых системах
Материалы научных исследований автора
Людмила Степановна Марценюк - ISBN: 978-3-659-68381-7
Аудит консолидированной отчетности холдинга
Теоретические аспекты и практическая реализация
Константин Авдиенко - ISBN: 978-3-659-68222-3